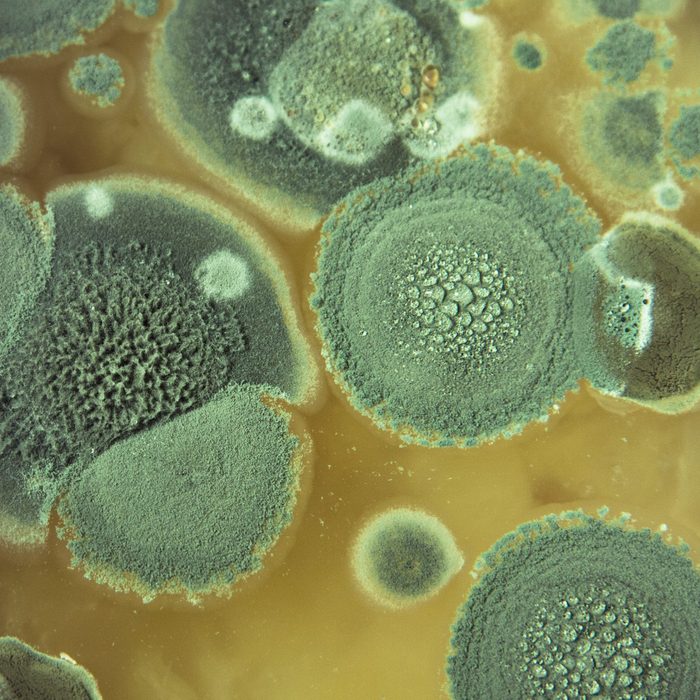
Aspergillus fumigatus

Wondering what kind of mold is growing in your bathroom? Learn about common bathroom mold species and whether they're cause for concern.
9 Bathroom Mold Types To Be Aware Of
Aspergillus
Considered a common indoor mold, aspergillus includes hundreds of species. In a bathroom, it may grow near water leaks or on shower walls.
It’s black and gray, or white and yellow. It can grow in large patches with a short, fuzzy surface texture.
Those with mold allergies or asthma conditions are most at risk. According to Carver, this mold can “cause a severe asthmatic reaction in people with asthma who are sensitive to this mold type.”
An especially dangerous strain sometimes found in the bathroom is aspergillus niger. If someone immunocompromised breathes it in, it can begin to grow in the lung tissue and cause aspergillosis, a potentially serious respiratory disease.
Dogs can also have allergic reactions or can develop aspergillosis, with potentially grave results.

Cladosporium
Another common mold in bathrooms, cladosporium can grow around tubs and drains, under sinks and on drywall, window frames and wallpaper. Fabric items like shower curtains, bath mats and towels can also host cladosporium.
“Mold spores are constantly looking for some sort of organic material to grow on, like those found in most building materials,” Sacenti says.
Cladosporium can be identified by its often olive green, brown or black color, and circular patches. It can cause asthma and allergy symptoms in otherwise healthy people. In rare cases, it can cause more serious infections and conditions like fungal sinusitis.
Those with existing asthma may find their symptoms amplified with exposure to cladosporium. “Everybody’s respiratory system is different, and will react to mold differently,” Sacenti says.
In pets, cladosporium can cause dangerous infections of the central nervous system, lungs and kidneys.

Penicillium
You may have seen penicillium on moldy bread or fruit in your kitchen, but it can also develop in the bathroom. Look for it on window frames, drywall or on bathroom faucets and drains.
You’ll recognize penicillium from its bluish green color and fuzzy texture. It can also cause surface damage, so even after removal, stains and pitted areas may remain.
Penicillium can pose health risks to those with compromised immune systems or pre-existing allergies and asthma. It can cause respiratory infections as well.
Ingesting penicillium can make a dog really ill. Exposure usually occurs from eating moldy food.

Stachybotrys
Also known as ‘black mold,’ stachybotrys “thrives in wet conditions, and especially in wood, drywall or wallpaper,” Carver says. It requires a constant source of moisture to grow, so unknown plumbing leaks and condensation buildup in poorly ventilated bathrooms are a common cause.
As its common name implies, stachybotrys is black. It often has a distinct, musty smell that’s sometimes the first sign of a problem. In the case of plumbing leaks, black mold can begin inside the wall. Although it’s not yet visible, it can be identified by the smell.
Much has been made about the dangers of black mold, for good reason. Exposure has been linked to respiratory difficulties, chronic headaches, fatigue and depression.
Similar to other molds, prolonged exposure to stachybotrys can pose health threats for those with asthma, allergies and compromised immune systems.
In rare cases, black mold can cause fatal blood clotting complications when inhaled by dogs and cats.

Trichoderma
This pervasive mold can be found on bathroom walls, ceilings, wallpaper, wood trim and cloth shower or window curtains. It’s often found near plumbing leaks or in really humid bathrooms.
“If you’ve got a leak beneath the sink, you’ve got organic building material and a constant water source in a dark area, so it’s the perfect breeding ground,” Sacenti says.
During its life cycle, trichoderma changes from transparent to yellow and white before becoming gray and green when mature. Some species may smell like coconut.
Trichoderma exposure rarely effects healthy individuals, but can impact the asthmatic or those with allergic sensitivities, causing sneezing, coughing and sore throat.
For those with compromised immune systems, trichoderma can pose an elevated risk because it resists antifungal treatments.

Alternaria
Alternaria is one of the most common molds inside a home. It’s often found in sinks, showers and other areas where wetness lingers, Carver says.
Usually dark green or brown with a velvety texture, look for it on water-damaged drywall or wood, as well as tile and painted surfaces.
It can trigger allergic reactions in those with pre-existing sensitivities. Some species can also grow on human tissue, causing serious infections in people with compromised immune systems.
Alternaria is commonly associated with mold-related infections and allergies in pets.

Ulocladium
This common household mold can often be found on wood, drywall, wallpaper and fabrics exposed to water from a leaky pipe, high humidity or chronic condensation in a bathroom. Don’t be surprised if you find this growing on a wall or window frame near the shower or after severe water damage like a flood or burst pipe, says Carver.
Often mistaken for the other black mold, stachybotrys, ulocladium can be greenish-black, as well as brown or gray.
Ulocladium can cause minor and potentially major health issues. As an allergenic mold, it can cause itchy eyes, sneezing, congestion and headache in those with pre-existing allergies or asthma. It’s particularly concerning for those with compromised immune systems.

Aureobasidium
In bathrooms, aureobasidium can grow on moist surfaces like tile grout, tub caulking, shower walls, toilets, sinks and shower curtains.
Young colonies of aureobasidium are white, pink or orange, with a moist and slimy texture. As it matures, its color and texture can change to black and fuzzy. It often begins in the shower where it feeds off the organic compounds and residue left behind by soaps and shampoos.
“Soap scum in the water will migrate down to the caulked joint at the top of the tub,” Sacenti says, “That’s a common place to see this mold.”
When in an immature moist state, aureobasidium doesn’t pose a respiratory threat. But it can create health problems if it enters the body through the eyes, nose or mouth. This risk is especially high for immunocompromised individuals.
More mature colonies can produce spores that can irritate existing allergy and asthma conditions.
In pets, aureobasidium can cause illness if ingested or with prolonged exposure.

Chaetomium
One of the most potentially dangerous molds, chaetomium can be found on wood, drywall and wallpaper in a bathroom. It requires high moisture levels to grow, so it can often be found after episodes of water damage from flooding or plumbing leaks.
Chaetomium has a different appearance depending on its life cycle. When just beginning, it will be white, Sacenti says. As it matures and spores develop, it turns blue-green and dark brown or black. At this stage, chaetomium can be mistaken for stachybotrys or black mold. Another identifying feature: Its musty, damp-earth smell.
In the worst cases, this mold can cause serious or even fatal illness and brain infections. More typically, it bothers those with existing allergies and asthma. But it can also lead to nail and skin infections, so it should be treated with caution. If you suspect chaetomium in your bathroom, call a mold specialist.
Pets exposed to chaetomium can experience severe respiratory infections or allergic reactions.

Frequently Asked Questions
What causes mold in the bathroom?
All mold species love warm, damp and dark areas. Bathrooms provide a perfect environment. “The bathroom is the highest humidity environment in any home, including the basement,” Sacenti says, “You add in organic materials and warmth, and it creates perfect conditions for mold.”
How do you get rid of mold in the bathroom?
If you have allergies, asthma or a compromised immune system, call a mold remediation company.
For those without these conditions, if the mold is smaller than a three-foot by three-foot area, you can tackle it yourself with the appropriate cleaning agents and methods. Be sure to use protective gloves and a dust mask. “Most molds can be cleaned and removed with soap and water and white vinegar,” Carver says.
Larger molded areas should be left to a mold remediation company.
How can you prevent mold in the bathroom?
Help prevent bathroom mold by increasing ventilation. Open a window or turn on the bathroom fan while showering. Check for plumbing leaks, and dry your shower walls after use with a towel or a squeegee.
“Turn the bathroom fan on as soon as you enter the bathroom and leave it on for a while after you’re done showering,” Sacenti says. “It’s critical to manage the humidity levels in the bathroom.”
How do I know if I have mold or mildew in my bathroom?
Unlike mold, mildew is usually white or gray with a dry, powdery texture. Where mold tends to be fuzzy and raised, mildew is flat. Mold also has a distinct heavy, musty smell and mildew has a sharp, sour smell like rotting vegetables.
How common is bathroom mold?
Extremely common.
Also, find out how to clean black spots in the bathroom with a few supplies.
About the Experts
Michael Sacenti owns American Healthy Homes. He has 10 years of experience in the mold remediation industry and 40 years experience in real estate maintenance.
Melanie Carver is the chief mission officer for the Asthma and Allergy Foundation of America.
